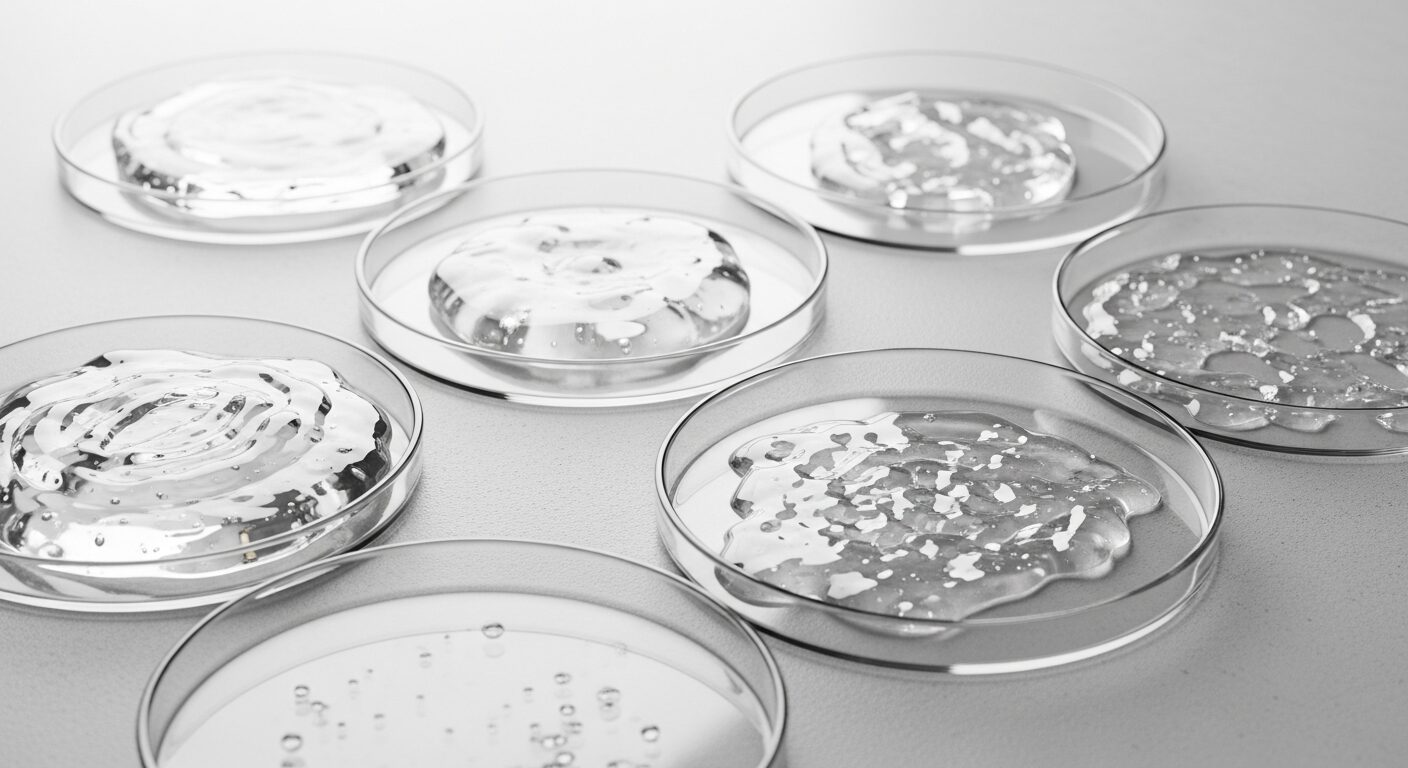
シリコーンの種類と機能を知る

「ジメチコンは髪に悪い」「毛穴が詰まる」といった噂を聞き、ジメチコン配合のトリートメントを避けていませんか。しかし、その多くは誤解かもしれません。ジメチコンはシリコーンの一種であり、その機能や安全性を正しく知ることが重要です。
この記事では、ジメチコンの効果は嘘ではない理由や、ノンシリコンとの違いとそれぞれの限界について詳しく解説します。
また、ダメージ毛へのアプローチやカラー・パーマへの影響、髪質別の賢い選び方まで、専門的な視点から最適なジメ-チコントリートメント選びの結論を導き出します。髪への蓄積(ビルドアップ)の解消法も紹介するので、ぜひ最後までご覧ください。
- ジメチコン(シリコーン)に関する正しい知識が身につきます。
- 安全性や毛穴詰まりといった不安や誤解が解消されます。
- 自分の髪質や悩みに合ったトリートメントを選べるようになります。
- 日々のヘアケアの質を高め、美しい髪を維持する方法がわかります。

ジメチコントリートメントの誤解と真実
- シリコーンの種類と機能を知る
- 安全性や頭皮への影響は本当か
- 毛穴詰まりは俗説の真相を解説
- ジメチコンの効果は嘘ではない理由
- 知っておくべきメリットとデメリット
- ノンシリコンとの違いとそれぞれの限界
シリコーンの種類と機能を知る
ジメチコンは、化粧品やヘアケア製品に広く使われている「シリコーン」の一種です。シリコーンと聞くと、漠然と化学的なものというイメージを持つかもしれませんが、実は様々な種類があり、それぞれ異なる役割を持っています。
大別すると、シリコーンには揮発性のものと非揮発性のものがあります。揮発性シリコーンは髪に塗布した後、時間とともに蒸発するため、軽い仕上がりになるのが特徴です。そのため、洗い流さないトリートメントオイルなどで使用されることがあります。
一方で、ジメチコンの多くは非揮発性シリコーンに分類されます。これは髪の表面に留まり、キューティクルをコーティングする役割を果たします。このコーティング作用により、指通りが滑らかになったり、ドライヤーの熱やブラッシングの摩擦から髪を守ったりする効果が期待できるのです。
シリコーンの主な種類と特徴
| 分類 | 代表的な成分名 | 主な特徴と役割 |
|---|---|---|
| 非揮発性シリコーン | ジメチコン、アモジメチコン | 髪表面に残り、保護膜を形成。指通りを良くし、ツヤを与える。持続性が高い。 |
| 揮発性シリコーン | シクロペンタシロキサン、シクロメチコン | 塗布後に蒸発する。ベタつきが少なく、サラッとした軽い使用感を与える。 |
| その他 | ジメチコノール | 粘度が高く、しっとりとした感触を与える。ダメージ補修効果を謳う製品にも配合。 |
このように、一口にシリコーンと言っても多種多様であり、製品の目的によって使い分けられています。
安全性や頭皮への影響は本当か

「シリコーンは髪や頭皮に悪い」というイメージが広まっていますが、これは本当なのでしょうか。結論から言うと、化粧品に使用されているジメチコンをはじめとするシリコーンは、通常の使用方法において安全性が確認されている成分です。
世界中の規制機関で安全性が評価されており、長年にわたり化粧品に使用されてきた実績があります。例えば、日本の化粧品基準でも使用が認められています。また、シリコーンは化学的に安定した物質であり、皮膚への刺激やアレルギー反応を引き起こしにくい性質を持つとされています。
シリコーン油は皮膚に浸透せず、毛穴に詰まることもないという調査結果もあります。そのため、頭皮に直接すり込むような使い方をしない限り、過度に心配する必要はないでしょう。
(参照:化粧品成分オンライン)
YMYL情報に関する注意
この記事で述べる健康や安全性に関する情報は、一般的な知見に基づくものです。特定の成分に対するアレルギーや過敏症など、個人の体質によっては合わない場合もあります。もし使用中に赤み、かゆみ、刺激等の異常が現れた場合は、すぐに使用を中止し、皮膚科専門医等に相談してください。
毛穴詰まりは俗説の真相を解説

ジメチコンに関する最も根強い俗説が「毛穴に詰まる」というものでしょう。この噂が広まったことで、ノンシリコンシャンプー市場が大きく成長した側面もあります。しかし、この説には科学的な根拠が乏しいのが実情です。
化粧品に使用されるジメチコンは、分子が大きく設計されています。そのため、毛穴の奥深くまで入り込んで詰まらせることは物理的に考えにくいとされています。むしろ、髪の表面を滑らかにコーティングすることが主な役割です。
では、なぜこのような俗説が広まったのでしょうか。一因として、過去の一部の粗悪な製品や、洗い残しによる頭皮トラブルが「シリコーンが原因」と誤って結びつけられた可能性が考えられます。現代の適切に設計されたシャンプーやトリートメントを使用し、しっかりとすすげば、毛穴詰まりを過度に恐れる必要はありません。
ジメチコンの効果は嘘ではない理由

ジメチコンの効果は、決して嘘や気休めではありません。その効果は、髪の物理的な性質に基づいています。ジメチコンは、髪の表面にあるキューティクルの凹凸を埋めるように均一な膜を形成します。
このコーティング作用によって、いくつかの明確なメリットが生まれます。第一に、髪同士の摩擦が軽減され、指通りが劇的に向上します。これにより、ブラッシング時の切れ毛や枝毛を防ぐことにつながります。
第二に、形成された膜が外部の刺激から髪を保護します。例えば、ドライヤーの熱や紫外線の影響を和らげる効果が期待できます。さらに、髪の内部からの水分蒸発を防ぐ役割も果たし、潤いを保つのに役立ちます。このように、ジメチコンは髪を「補修」するのではなく、「保護・コーティング」することで美しく見せ、扱いやすくしているのです。
知っておくべきメリットとデメリット

ジメチコントリートメントを賢く使うためには、メリットとデメリットの両方を理解しておくことが大切です。それぞれを把握し、自分の髪の状態や目的に合わせて判断しましょう。
ジメチコンのメリット
- 手触りと指通りの向上: 髪表面を滑らかにし、絡まりにくくします。
- ツヤ出し効果: 光を均一に反射させ、髪に美しいツヤを与えます。
- 外部刺激からの保護: ドライヤーの熱や摩擦、紫外線から髪を守ります。
- まとまりやすさの向上: 湿気による広がりを抑え、スタイリングしやすくなります。
- 即効性: 使用後すぐに効果を実感しやすいです。
一方で、デメリットや注意点も存在します。これらを理解しないまま使い続けると、かえって髪の悩みを増やす可能性もあります。
ジメチコンのデメリット
- ビルドアップの可能性: 連続使用で成分が髪に蓄積し、重さやゴワつきを感じることがあります。
- 髪質との相性: 猫っ毛や細い髪質の人が使うと、ボリュームダウンしてしまうことがあります。
- 根本的な補修ではない: あくまでコーティングによる対症療法であり、髪の内部を修復するわけではありません。
ダメージが深刻な髪には、ジメチコンによる保護が非常に有効です。特にハイダメージ毛のケアについては、こちらの記事も参考にしてください。
→ ケアブリーチ完全ガイド|髪への負担を減らす新常識
ノンシリコンとの違いとそれぞれの限界

ジメチコン入りトリートメントと比較されるのが「ノンシリコン」製品です。ノンシリコンは、その名の通りシリコーンを配合していない製品を指します。では、両者にはどのような違いがあり、それぞれにどんな限界があるのでしょうか。
ノンシリコントリートメントの最大のメリットは、仕上がりの軽さです。コーティング成分が少ないため、髪本来の質感(素髪感)を活かしたい方や、根元のボリュームを保ちたい方に向いています。しかし、その反面、保護力が弱いため、きしみやすかったり、ダメージを受けやすかったりする点がデメリットです。
対するジメチコン入りは、強力なコーティング力で髪を保護し、手触りを良くしますが、髪質によっては重く感じることがあります。つまり、どちらが優れているというわけではなく、一長一短なのです。
シリコン vs ノンシリコン 比較まとめ
| 項目 | ジメチコン(シリコン)入り | ノンシリコン |
|---|---|---|
| 仕上がり | しっとり、ツルツル、まとまりやすい | ふんわり、サラサラ、軽い |
| メリット | 指通り向上、ツヤ出し、保護力が高い | 根元のボリュームを維持、素髪感 |
| デメリット | 重くなりやすい、ビルドアップの可能性 | きしみやすい、保護力が低い |
| おすすめの人 | ダメージ毛、広がりやすい髪、ツヤが欲しい人 | 細毛・軟毛、ボリュームが欲しい人、健康毛 |
重要なのは、自分の髪質やなりたい仕上がりに合わせて、両者をうまく使い分けることです。
お客様の「なんだかスッキリしない…」
その“本音”、見過ごしていませんか?
アンケートで、実に65%ものお客様が不満を感じていた「首まわりの洗い残し」。
この“サイレントクレーム”が、あなたのサロンの失客原因になっているとしたら…?
いつものシャンプー台が、生まれ変わります。
- お客様が「ここのシャンプーは違う」と感動する洗い心地を実現
- 技術の差が出にくく、誰が担当しても常に最高の満足を提供
- “感動シャンプー”がお店の代名詞となり、口コミとリピートを生み出す
価格競争から、完全に抜け出しませんか?
シャンプーで圧倒的な差別化を図り、お客様がファンになるサロンへ。
そのための具体的な方法を、今だけ限定公開しています。
正しいジメチコントリートメントの選び方
- ダメージ毛へのアプローチと効果
- カラーやパーマへの影響について
- 髪への蓄積とビルドアップ解消法
- 髪質別の使い方と賢い選び方
- 最適なジメチコントリートメント選びの結論
ダメージ毛へのアプローチと効果

ヘアカラーやパーマ、毎日のヘアアイロンなどでダメージを受けた髪にとって、ジメチコントリートメントは非常に有効なケアアイテムとなり得ます。ダメージ毛は、髪の表面を覆うキューティクルが剥がれたり、めくれたりしている状態です。
この状態を放置すると、髪内部のタンパク質や水分が流出し、パサつきや切れ毛がさらに進行してしまいます。そこでジメチコンの出番です。ジメチコンが剥がれたキューティクルの代わりのように髪表面をコーティングし、擬似的な保護膜を形成します。
これにより、手触りが改善されるだけでなく、髪内部の栄養分が流れ出るのを防ぎ、外部からのさらなるダメージを抑制する効果が期待できます。ダメージがひどいほど、ジメチコンによるコーティングの恩恵は大きくなると言えるでしょう。ただし、これはあくまで対症療法であり、髪の内部から補修する成分と併用することが理想的です。
カラーやパーマへの影響について

「シリコーンが髪に残っていると、カラーやパーマがかかりにくくなる」という話を聞いたことがあるかもしれません。これは一部事実ですが、過度に心配する必要はありません。
確かに、髪にシリコーンが過剰に蓄積していると、薬剤の浸透を妨げる可能性があります。しかし、美容室での施術前には、通常シャンプーで髪の汚れや付着物を洗い流します。そのため、日常的なトリートメントの使用が、一度で施術に致命的な影響を与えることは稀です。
むしろ、カラーやパーマ後のケアとしてジメチコントリートメントは非常に有用です。施術後の髪はアルカリ性に傾き、キューティクルが開いてダメージを受けやすい状態になっています。ジメチコンでコーティングすることで、キューティクルを保護し、染料の流出を穏やかにして色持ちを良くしたり、パーマのカールを維持しやすくしたりする効果が期待できます。施術の順番や薬剤知識について興味がある方は、関連記事: カラーとパーマの順番|髪への負担を減らす最適解 もご覧ください。
より詳しい成分情報については、化粧品成分オンラインのような専門サイトで個別の成分を調べることも参考になります。
髪への蓄積とビルドアップ解消法

ジメチコントリートメントを使い続ける上で注意したいのが、「ビルドアップ」と呼ばれる現象です。ビルドアップとは、シリコーンなどのコーティング成分が洗い流されずに髪に蓄積していく状態を指します。
ビルドアップが起こると、最初はツルツルだった髪が、次第にゴワゴワしたり、ベタついて重く感じたりすることがあります。また、トリートメント成分が髪の内部に浸透しにくくなる原因にもなります。
この問題を解消するためには、定期的な「リセットケア」が効果的です。具体的には、週に1〜2回程度、洗浄力の高いシャンプー(クレンジングシャンプーや炭酸シャンプーなど)を使い、髪に蓄積したシリコーンや汚れをしっかりと洗い流しましょう。
ビルドアップ解消のステップ
- クレンジングシャンプーの使用: 週1~2回、普段のシャンプーを洗浄力の高いものに置き換えます。
- しっかり泡立てて洗う: 髪だけでなく、頭皮まで指の腹で優しくマッサージするように洗います。
- 念入りにすすぐ: シャンプー剤が残らないよう、普段より時間をかけて丁寧に洗い流します。
- 集中トリートメント: "素髪"になった状態の髪に、保湿・補修成分が豊富なトリートメントをしっかりなじませます。
このリセットケアを取り入れることで、ジメチコンのメリットを享受しつつ、デメリットであるビルドアップを防ぐことができます。
髪質別の使い方と賢い選び方

ジメチコントリートメントの効果を最大限に引き出すには、自分の髪質に合った製品を選び、適切な使い方をすることが重要です。ここでは代表的な髪質別に、選び方のポイントを解説します。
【細毛・軟毛・猫っ毛の方】
ボリュームが出にくく、ペタッとなりやすい髪質の方は注意が必要です。高濃度のジメチコンや重いオイルが主体の製品は避け、比較的軽い仕上がりのものを選びましょう。揮発性シリコーン(シクロペンタシロキサンなど)がメインで配合されている製品や、洗い流すタイプでも「サラサラ」「ふんわり」を謳うものがおすすめです。また、毛先中心につけ、根元にはつけないように意識することも大切です。
【太毛・硬毛・くせ毛の方】
髪が広がりやすく、まとまりにくい髪質の方には、ジメチコントリートメントは非常に相性が良いです。ジメチコンやアモジメチコンといった非揮発性シリコーンがしっかり配合された、しっとり系の製品を選ぶと、髪の広がりを抑え、まとまりとツヤを与えてくれます。オイルタイプの洗い流さないトリートメントも効果的です。
【ハイダメージ毛の方】
ブリーチや縮毛矯正を繰り返しているハイダメージ毛の方は、保護力が最も重要です。ジメチコンによるコーティングは必須とも言えます。加えて、内部補修成分であるケラチンやセラミドなどが配合された製品を選ぶと、内外からのダブルケアが可能です。花王のヘアケアサイトなど大手メーカーの製品情報も、成分選びの参考になります。(参照:花王 ヘアケアサイト)
最適なジメチコントリートメント選びの結論
これまで解説してきた内容を踏まえ、この記事の結論として、最適なジメチコントリートメント選びの要点をまとめます。以下のリストを参考に、日々のヘアケアを見直してみてください。
- ジメチコンは髪をコーティングし、指通りを良くする安全な成分である。
- 「毛穴に詰まる」「髪に悪い」という噂は、多くが科学的根拠の乏しい俗説である。
- ジメチコンのメリットは、即効性のあるツヤ出し、保護効果、まとまり向上である。
- デメリットは、ビルドアップによる重さや、髪質によってはボリュームダウンすることである。
- ノンシリコンは仕上がりが軽いが、保護力が低くきしみやすいという限界がある。
- ダメージ毛には、キューティクルを保護するジメチコンの効果は特に高い。
- カラーやパーマ後のケアとして使うと、色持ちやカールの維持に貢献する。
- ビルドアップを感じたら、週に1〜2回クレンジングシャンプーでリセットする。
- 細毛・軟毛の人は、軽い仕上がりの製品を毛先中心に使うのがおすすめ。
- 太毛・硬毛の人は、しっとりまとまるタイプの製品と相性が良い。
- ハイダメージ毛の人は、内部補修成分とジメチコンが両方入った製品を選ぶと効果的。
- 成分表示を見て、どのようなシリコーンが使われているか確認する習慣をつける。
- ジメチコンとノンシリコンを、髪の状態やなりたいスタイルによって使い分けるのが賢い選択。
- トリートメントは毛先から中間につけ、頭皮には直接つけないようにする。
- 最終的なすすぎを丁寧に行うことが、トラブルを防ぐ基本である。